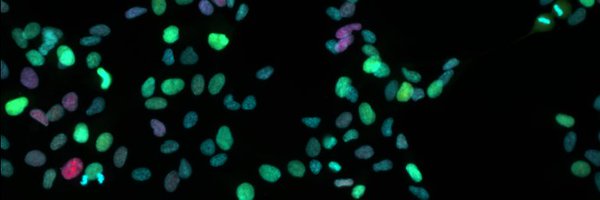
sandhya_manohar Profile Banner

Sandhya Manohar
@sandhya_manohar
Followers
456
Following
4K
Media
47
Statuses
617
@snsf_ch Ambizione group leader studying why big cells break bad @UZH_en | cell size, cell cycle, distance running | Metzgerin der deutschen Sprache | she/her
Zürich, CH
Joined January 2013
We're primarying John Fetterman. Last week, Fetterman once again sold out working Pennsylvanians. He was the deciding vote for a Republican budget bill that will strip healthcare from over 400,000 Pennsylvanians. We deserve real working class leadership in the U.S. Senate.
838
3K
19K
Now that we've reached a critical mass-- 3 whole people!!-- our lab website got a little glow up ✨ check us out:
manohar-lab.com
0
0
5
Narrator: He did not fight
Health care is a basic, fundamental human right. I will fight for health care like the health care that saved my life. #PASenateDebate
37
5K
59K
I'm not one for purity tests, but... Any "Democrat" who supports right-to-work should be exiled from the party.
Abigail Spanberger, Democrat running for Virginia Governor, says she wouldn't sign a bill that fully repeals right-to-work. Any politician who wants to serve working Americans needs to unequivocally stand against anti-union right-to-work laws and support the labor movement.
35
239
3K
Pennsylvania has an important Supreme Court race coming up on Tuesday, November 4. If you live in the Keystone State, or know someone who does, vote YES to retain three justices who will protect your fundamental rights and freedoms. It’s never been more important to support men
iwillvote.com
Be a voter. Find everything you need to vote in your state’s next election.
15K
16K
67K
I generally don’t think grades are a great metric of who absorbed the material best, but I had o-chem 2 students at Harvard who got Bs making five bonds to carbon the whole semester….that shouldn’t happen
These Harvard students…did not react well to the report on grade inflation: “The whole entire day, I was crying. I skipped classes on Monday, and I was just sobbing in bed because I felt like I try so hard in my classes, and my grades aren’t even the best. It just felt
0
0
0
Harvard reports that it is “failing to perform the key functions of grading.” Its grading practices are “damaging the academic culture of the College.” “Faculty newly arrived at Harvard are surprised at how leniently our courses are graded.” Students say academics feel “fake.”
106
294
2K
Anyone who tests AI on their area of expertise rapidly realizes that AI is an idiot. Unfortunately, it is becoming clear to me that many humans do not have an area of expertise.
1K
4K
36K
New work from the Hemingway lab! If you wanna know how much carbon was floating around in the ocean a billion years ago, you should check it out. Congrats to all authors but especially to my science and everything else icon, #twitterless Jordon Hemingway
nature.com
Nature - A direct proxy for past dissolved organic carbon signatures using co-precipitated organic carbon in iron ooids enables reconstruction of marine dissolved organic carbon signals dating back...
0
4
14
New work from the lab: Identification of CNOT1-CCR4-NOT as a suppressor of 53BP1-p53-p21 signaling @CellReports. Congratulations to first author Antonio Galarreta and to all co-authors. https://t.co/WE2QHsIs0S.
#Microscopy #RNAiScreen #Condensates
1
10
40
Palestinian statehood is a right. Not leverage to use against Israel.
168
3K
13K
good but “partial” is not enough; not one cent should be going to a country committing crimes against humanity.
We have proposed to partially suspend Israel's participation to Horizon Europe, specifically concerning the participation of entities established in Israel in activities funded under the Accelerator of the European Innovation Council.
0
1
2
Excited to announce that this work is now live as a first release article @ScienceMagazine So grateful for this fantatic team and to see this work in wild!
science.org
Charting the spatiotemporal dynamics of cell fate determination in development and disease is a long-standing objective in biology. Here, we present the design, development, and extensive validation...
1/14 On behalf of the amazing team in @JswLab, we’re excited to share PEtracer ( https://t.co/QTyBahCCLS) a prime editing-based evolving lineage recorder compatible with both scRNA-seq and high-resolution imaging readouts in intact tissue. By applying PEtracer in a syngeneic mouse
6
18
91
📣In a collaboration with the @amcdarnell , we discuss the complexity of the ribosome ubiquitin code and what the field has done to crack it! "The ribosome ubiquitination code: fine-tuning translation under stress" Read it here:
2
6
22
Letizia presented the first results of her PhD project at the ~legendary~ Salk Cell Cycle Meeting a few weeks ago! super grateful to have the opportunity to train the next generation of cell cycle enthusiasts 🙌🏽
1
1
15